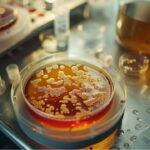

سینتیک رشد میکروبی – به زبان ساده
میکروبها موجودات پروکاریوتی و یوکاریوتی هستند که در زیستگاههای متفاوت پراکنده شدهاند. این موجودات بسیار کوچک سرعت رشد بیشتری نسبت به جانوران و گیاهان دارند. از میکروبها در صنایع مختلف برای تولید بعضی از موادغذایی، داروها و پروتئینهای نوترکیب استفاده میشود. آزمایشها و تولیدات صنعتی به تعداد زیادی سلول نیاز دارد. به همین دلیل اولین گام برای استفاده از این موجودات در صنایع کشت و تکثیر آنها است. محیطهای کشت صنعتی نسبت به محیطهای آزمایشگاهی بزرگتر هستند و امکان تکثیر باکتریهای بیشتر در زمان کوتاهتر را فراهم میکنند. آشنایی با سینتیک رشد میکروبی به تهیه محیط کشت کارآمدتر برای کشت میکروبها کمک میکند.
- خواهید آموخت که چگونه سینتیک رشد میکروبی در تولید صنعتی مؤثر است.
- میآموزید شرایط و روشهای مختلف کشت میکروبی را مقایسه کنید.
- مراحل رشد سلول و منحنیهای رشد را به درستی تحلیل میکنید.
- یاد میگیرید پارامترهای کلیدی رشد و بازدهی سلولی را محاسبه کنید.
- با ویژگیهای انواع روشهای اندازهگیری رشد میکروبی آشنا میشوید.
- تاثیر عوامل محیطی مانند دما، pH، و اکسیژن را بر رشد میشناسید.

سینتیک رشد میکروبی، سرعت رشد میکروبها در واحد زمان را نشان میدهد. سرعت رشد میکروبها به مواد غذایی و سایر عوامل محیطی ازجمله نور، گرما، اکسیژن، رطوبت و دما بستگی دارد. محاسبه سرعت رشد میکروبها و میزان موادغذایی مورد نیاز برای رسیدن به حداکثر سرعت رشد، به بهینهسازی تولید محصولات صنعتی و آزمایشگاهی کمک میکند. در این مطلب از مجله فرادرس سینتیک رشد میکروبی را همراه روشهای اندازهگیری رشد و عوامل موثر بر رشد میکروبی توضیح میدهیم.
سینتیک رشد میکروبی چیست؟
سینتیک رشد میکروبی رابطه بین سرعت رشد میکروبی و غلظت مواد موجود در محیط کشت میکروب را نشان میدهد و معیار مهمی در میکروبیولوژی است که به مطالعات فیزیولوژی، ژنتیک، اکولوژی و بیوتکنولوژی میکروبها کمک میکند. بهطور کلی رشد میکروبی را میتوان شبیه واکنش شیمیایی در نظر گرفت که در یک طرف آن سلولهای اولیه موادغذایی محیط کشت را مصرف میکنند و در طرف دیگر آن سلولهای بیشتر و ترکیبات حاصل از تجزیه موادغذایی تولید میشود. تعداد میکروارگانیسمها با تقسیم سلولی افزایش مییابد.
اما همیشه رشد میکروارگانیسمها با افزایش تعداد آنها همراه نیست. در بعضی از شرایط سلولها از انرژی برای تولید موادغذایی (ازجمله گلیکوژن و بتا هیدروکسی بوتیرات) و ذخیره آن استفاده میکنند. در این شرایط تعداد سلولها افزایش نمییابد اما «وزن توده سلولی» (Biomass) افزایش مییابد یا در بعضی از قارچها اندازه میکروارگانیسم بدون افزایش تعداد سلولها افزایش مییابد. بررسی سینتیک رشد میکروبی به فراهم کردن شرایط رشد مناسب برای بهدست آوردن محصول بهتر کمک میکند. در ادامه این مطلب از مجله فرادرس ابتدا انواع محیط کشت و سینتیک میکروبها در هر محیط را توضیح میدهیم. در ادامه روشهای اندازهگیری رشد میکروبی در محیط کشت و عوامل محیطی موثر بر رشد میکروبها را بررسی میکنیم.
روش های کشت میکروب
میکروبها را میتوان در محیطهای آزمایشگاهی و صنعتی با روشهای متفاوت کشت داد. تفاوت اصلی روشهای کشت آزمایشگاهی و صنعتی، حجم سلولها و محیط کشت است. در کشت صنعتی به تعداد بیشتر میکروب برای تولید محصولات مختلف نیاز است. در صنایع میکروبها را در سیستمهایی کشت میدهند که حجم زیادی دارد و میتوان دما، pH و اکسيژن آن را کنترل کرد. به این سیستمها فرمانتور یا بیوراکتور گفته میشود.
در بسیاری از فرایندهای صنعتی از محیطهای مایع برای کشت میکروبها استفاده میشود. اما برای رشد بعضی از میکروارگانیسمها بهویژه قارچها به محیط کشت جامد نیاز است. لازم به ذکر است اگه به مطالب بیشتر برای یادگیری روشهای کشت میکروبی علاقهمند هستید، فیلم آموزش میکروبیولوژی بخش یکم فرادرس که لینک آنها در ادامه آمده است به شما پیشنهاد میشود.

روشهای کشت میکروبی در محیطهای مایع را میتوان به سه دسته اصلی کشت غیرمدام، مدام و غیرمدام با خوراکدهی پیوسته تقسیمبندی کرد. در کشت غیرمداوم، «Batch» یا بسته، مصرف موادغذایی و تولید محصولات مختلف در فرایند رشد، ترکیب مواد شیمیایی محیط کشت را تغییر میدهد. در این محیطها با گذشت زمان موادغذایی لازم برای رشد باکتری کاهش مییابد. در این سیستمها تنها دما، pH و اکسیژن در زمان رشد میکروارگانیسمها تغییر میکند.
در کشت مداوم یا باز، در طول رشد حجم مشخصی از مواغذایی به محیط کشت اضافه و حجم برابر با آن از محیط کشت خارج میشود. در این نوع کشت حجم محیط، تعداد سلولها، غلظت موادغذایی و محصولات ثابت است. در کشت غیر مداوم با خوراکدهی پیوسته یا «Fed-Batch» مراحل اولیه کشت شبیه روش غیرمداوم است. اما با افزایش تعداد میکروبها، موادغذایی به محیط کشت اضافه میشود اما محیط کشت از فرمانتور خارج نمیشود.
رشد میکروبی در کشت غیرمداوم
باکتریها بهوسیله تقسیم دوتایی تکثیر میشوند. در تقسیم دوتایی یک باکتری به دو سلول کاملا شبیه هم تقسیم میشود. به این ترتیب از یک باکتری در نسل ۲ سلول، از تقسیم دو باکتری در نسل دوم ۴ سلول و از تقسیم چهار باکتری در نسل سوم ۸ سلول به وجود میآید. بر این اساس تعداد باکتریها در هر نسل را میتوان از محاسبه کرد. n نسل باکتریها است. به باکتریهای حاصل از هر تقسیم یک نسل و به مدت زمانی که برای دو برابر شدن تعداد باکتریها نیاز است، زمان تولید نسل گفته میشود. رشد میکروبها را میتوان بهوسیله نمودار نشان داد. نمودار رشد میکروبی غلظت سلولهای محیط کشت در واحد زمان را نشان میدهد. این نمودار در محیط کشت بسته به مراحل رشد تاخیری، رشد لگاریتمی، حالت ایستا و مرگ سلولی تقسیم میشود.
مرحله تاخیری نمودار رشد میکروبی
در مرحله تاخیری میکروب با محیط جدید سازگار میشود. اگر محیط کشت قبلی میکروب شبیه محیط کشت جدید باشد مرحله تاخیری بسیار کوتاه است و میکروب بلافاصله وارد مرحله رشد لگاریتمی میشود. مرحله تاخیری زمانی ایجاد میشود که میکروبها از یک محیط غنی وارد محیطی با موادغذایی کم میشوند. در این شرایط سلول برای سنتز آنزیمها و متابولیتهایی که در محیط وجود ندارد، نیاز به زمان دارد.
سلولها معمولا از محیطی که غلظت نمک و فشار اسمزی کمتری دارد وارد محیط با غلظت نمک و فشار اسمزی بیشتر میشود و در فاز لگاریتمی با فشار اسمزی محیط جدید سازگار میشود. به علاوه سن میکروارگانیسمها، مورفولوژی سلولها و غلظت نمونه میکروبی اولیه (مایه تلقیح) در تغییر زمان تاخیر نقش دارد. بهطور کلی اگر نمونه اولیه از میکروبهایی که در فاز لگاریتمی رشد هستند انتخاب شود، دوره تاخیر کاهش مییابد.

مرحله رشد لگاریتمی نمودار رشد میکروبی
در مرحله رشد لگاریتمی تعداد سلولها در بازه زمانیهای مشخص دو برابر میشود. این بازه زمانی در بعضی از میکروارگانیسمها چند دقیقه، در بعضی چند روز و در بعضی چند هفته است. سرعت تقسیم سلولها به شرایط محیط کشت و ژنتیک میکروارگانیسم بستگی دارد. به طور کلی سرعت رشد پروکاریوتها از یوکاریوتها و یوکاریوتهای کوچک از یوکاریوتهای بزرگ، بیشتر است. متابولیتهای اولیه میکروبها در این مرحله تولید میشود. این ترکیبات در رشد و فیزیولوژی میکروبها نقش حیاتی دارند. کربوهیدراتها، ویتامینها، آمینواسیدها و پروتئینها متابولیتهای اولیه هستند. در این حالت که موادغذایی کافی در دسترس سلول است، تعداد سلولها با وزن توده سلولی ارتباط مستقیم دارد. در این مرحله اندازه سلولها ثابت است. در نتیجه سرعت رشد ویژه میکروارگانیسمها با سرعت دو برابر شدن تعداد سلولها ارتباط مستقیم دارد. اگر میخواهید اطلاعات بیشتری راجع به آمینواسیدها داشته باشید، میتوانید مطلب مربوط به آمینواسیدها را در مجله فرادرس مطالعه کنید و اطلاعات بهتر و بیشتری کسب کنید.
مرحله ایستا نمودار رشد میکروبی
سلولها تا زمان رسیدن به حداکثر سرعت رشد () به تکثیر و افزایش جرم ادامه رشد لگاریتمی سلولها به دلیل کاهش موادغذایی محیط یا تجمع مواد زائد پس از مدتی کاهش مییابد و میکروارگانیسمها وارد مرحله ایستا میشوند. در این مرحله تعداد سلولهایی که از بین میرود با تعداد سلولهای جدید برابر است. متابولیتهای ثانویه در انتهای فاز لگاریتمی و این مرحله تولید میشوند. این متابولیتها از تغییر متابولیتهای اولیه در واکنشهای بیوشیمیایی تولید میشوند. بسیاری از ترکیباتی که در صنعت استفاده میشود متابولیتهای ثانویه باکتریها است. برای مثال سیتریکاسید یکی از متابولیتهای ثانویه میکروبها و اسیدهای آلی است که در صنایع غذایی کاربرد فراوانی دارد. در این مرحله بین تقسیم سلولی و جرم توده سلولی ارتباط مستقیم وجود ندارد. مرحله ایستا بر اساس نوع میکروارگانیسمها و شرایط محیط کشت متفاوت است.
مرحله مرگ نمودار رشد میکروبی
رشد میکروارگانیسمها در کشت غیرمداوم، محدود است. پس از مدتی به دلیل کاهش موادغذایی ضروری (منبع کربن، منبع نیتروژن، آمنیواسیدهای ضروری و سایر موادغذایی) یا افزایش ترکیبات سمی (ازجمله اتانول و لاکتیکاسید) محیط رشد میکروارگانیسمها کاهش مییابد و در نهایت متوقف میشود. در این مرحله تعداد سلولها بهشکل لگاریتمی کاهش مییابد. در این مرحله سرعت مرگ میکروبها بسیار کمتر از سرعت رشد سلولها در مرحله لگاریتمی است و ممکن است ماهها زمان نیاز داشته باشد.
رشد میکروبی در کشت مداوم
روشهای کشت مداوم در صنایع و آزمایشگاههای تحقیقاتی کاربرد زیادی دارند. در این روش کشت میتوان علاوه بر رشد سلولها، فیزیولوژی و فرایندهای بیوشیمیایی سلولها را در بازه زمانی بیشتر نسبت به کشت غیرمداوم بررسی کرد. مهمترین تفاوت این روش کشت با روش غیرمداوم این است که مرحله رشد لگاریتمی میکروارگانیسمها در این روش برای مدت طولانی ادامه دارد.
متداولترین روش کشت مداوم استفاده از «کموستات» (Chemostat) است. در این دستگاه از محیط کشت مایع استفاده میشود. سرعت رشد ویژه و چگالی میکروبها (تعداد سلولها در هر میلیلیتر محیط کشت) را میتوان در کموستات کنترل کرد. سرعت رشد ویژه به سرعت رقیق شدن (نسبت سرعت ورود و خروج مایع کشت به حجم محیط کشت) و چگالی سلولها به غلظت ماده غذایی محدودکننده (موادغذایی که برای رشد میکروب ضروری است مثل منبع کربن و نیتروژن) بستگی دارد. در این سیستم سرعت رشد و چگالی میکروبها مستقل از هم تنظیم میشوند.

زمانی که کموستات تازه از محیط کشت پر و انکوبه شده است، سرعت رشد باکتریها بیشتر از سرعت خروج مایع کشت از کموستات است. با افزایش تعداد سلولها، غلظت ترکیب محدودکننده کاهش مییابد. کاهش ماده غذایی محدودکننده، سرعت رشد میکروب را کاهش میدهد. با توجه به این نکته که میکروبها همراه محیط کشت از کموستات خارج میشوند، کاهش سرعت رشد با کاهش چگالی سلول همراه است. زمانی که ترکیب محدودکننده به غلظتی رسید که سرعت رشد برای جبران باکتریهایی خروجی کافی بود، سیستم وارد حالت ایستا میشود. در این حالت سرعت رشد و چگالی میکروبها در طول زمان ثابت است.
در حالت ایستا سرعت افزایش تعداد سلولها به دلیل رشد با سرعت کاهش تعداد سلولها به دلیل خروج محیط کشت برابر است. در نتیجه در حالت ایستا کشت مداوم، سرعت رشد ویژه میکروبها با سرعت رقیق شدن محیط کشت (D) برابر است. وابستگی سرعت رشد به غلظت ترکیب محدودکننده یک مکانیسم خودتنظیمی در کموستات ایجاد میکند. در نتیجه میتوان با تغییر سرعت رقیق شدن محیط کشت، سرعت رشد میکروبها را تنظیم کرد. زمانی که سرعت رقیق شدن بسیار کم است، میکروب ترکیب محدودکننده را به جای رشد، برای انجام فرایندهای ضروری مصرف میکند. به همین دلیل چگالی سلولها کاهش مییابد.
محاسبه رشد میکروب در کشت غیرمداوم
محاسبه میزان و سرعت رشد باکتریها در فرایندهای صنعتی بسیار مهم است و به طراحی سیستمهایی با بیشترین بازدهی و کمترین هزینه کمک میکند. به علاوه انتخاب محیط کشت و بیوراکتور مناسب در افزایش بازدهی کشت صنعتی میکروارگانیسمها نقش دارد. اگر به یادگیری بیشتر مباحث میکروبیولوژی صنعتی علاقه دارید، مشاهده فیلمهای آموزشی فرادرس که در این رابطه تهیه شده است، به شما پیشنهاد میشود.

میزان رشد میکروبها و میزان مصرف موادغذایی در دوران رشد باکتریها را میتوان با معادلات ریاضی محاسبه کرد. رشد لگاریتمی میکروارگانیسمها در محیط بسته را میتوان بر اساس جرم (x) یا بر اساس تعداد سلولها (N) محاسبه کرد. برای محاسبه رشد لگاریتمی بر اساس توده سلولی، رشد را میتوان واکنشی در نظر گرفت که یکی از محصولات آن کاتالیزور واکنش است. در این حالت سرعت رشد به غلظت توده سلولی در واحد زمان بستگی دارد. این رابطه را میتوان با معادله ریاضی زیر نشان داد. در این معادله dx تغییرات توده سلولی (گرم بر لیتر)، سرعت رشد ویژه (یک بر ساعت) و dt تغییرات زمان (ساعت) است.
در این حالت نمودار تغیییرات سلولی در واحد زمان، منحنی است که شیب آن بهطور پیوسته افزایش مییابد.

با تغییر معادله بالا، سرعت رشد ویژه میکروبها را میتوان از معادله زیر محاسبه کرد.
اما رشد لگاریتمی واقعی میکروارگانیسم را با توجه به این نکته که در هر نسل سلول به محیط اضافه میشود، میتوان از معادله زیر محاسبه کرد. در این معادله غلظت توده سلولی پس از گذشت t و غلظت توده سلولی در شروع رشد لگاریتمی و e پایه لگاریتم طبیعی (ln) است.
اگر از معادله بالا لگاریتم بگیریم، غلظت توده سلولی میکروارگانیسم از معادله زیر محاسبه میشود. نمودار حاصل از این معادله خطی است. در نمودار این معادله y و عرض از مبدا و شیب خط (سرعت رشد ویژه) است.
در توضیح مرحله مرگ میکروارگانیسمها به این نکته اشاره کردیم که رشد سلولها با کاهش موادغذایی کاهش مییابد. بر این اساس میتوان گفت رشد میکروارگانیسم به غلظت ترکیب محدودکننده بستگی دارد. ترکیب محدودکننده مادهای است که رشد باکتری بدون آن غیرممکن است. اگر رشد میکروارگانیسمها یک واکنش بیوشیمیایی در نظر بگیریم، سرعت رشد باکتریها را میتوان از معادلهای شبیه به معادله میکائیلیس منتن محاسبه کرد. در معادله زیر حداکثر سرعت (یک بر ساعت) رشد باکتری زمانی که غلظت تمام ترکیبات زیاد است و ترکیب محدودکننده نداریم، S غلظت ترکیب محدودکننده (گرم بر لیتر) است، غلظتی از ترکیب محدودکننده را نشان میدهد که سرعت رشد در آن غلظت نصف است.
تولید متابولیتهای اولیه به سرعت رشد ویژه بستگی دارد. به همین دلیل محاسبه در فرایندهای صنعتی بسیار مهم است. به علاوه برای اینکه فرایند صنعتی بیشترین کارایی را داشته باشد، میکروارگانیسمها باید شرایطی برای میکروارگانیسمها فراهم شود که با حداکثر سرعت رشد کنند. با محاسبه حداکثر سرعت رشد در چند کشت غیرمداوم که غلظت ترکیب محدودکننده در آنها متفاوت است، میتوان را محاسبه کرد.
ضریب بازدهی یکی دیگر از پارامترهای مهم در سینتیک رشد میکروبی است. این پارامتر بر اساس ترکیب محدودکننده محاسبه میشود. این ترکیب معمولا کربوهیدراتی است که با واکنشهای آنزیمی میکروارگانیسم به محصول تبدیل میشود. ضریب بازدهی بر اساس جرم توده سلولی با معادله زیر محاسبه میشود. در این معادله x غلظت توده سلولی (گرم بر لیتر)، Y ضریب بازدهی (گرم توده سلولی بر کرم ترکیب محدودکننده)، S غلظت اولیه ترکیب محدودکننده (گرم بر لیتر)، غلظت باقیمانده از ترکیب محدودکننده (گرم بر لیتر) است.
بر این اساس ضریب بازدهی به میزان توده سلولی تولید شده به ازای هر گرم ترکیب محدودکننده بستگی دارد. در نتیجه هر چه ضریب بازدهی بیشتر باشد مقدار بیشتری از ماده اولیه به توده سلولی تبدیل شده است. تعیین ضریب بازدهی به این دلیل مهم است که بخش زیادی از هزینههای تولید به ترکیب محدودکننده محیط کشت بستگی دارد.
محاسبه رشد میکروبی در کشت مداوم
در بخش قبلی مطلب سینتیک رشد میکروبی رابطه سرعت رشد میکروبها با غلظت مواد در کشت غیرمداوم را توضیح دادیم در این بخش قصد داریم رابطه سرعت رشد میکروب و غلظت موادغذایی را در کشت مداوم بررسی کنیم. سرعت رقیق شدن محیط در کشت مدام را میتوان با معادله زیر محاسبه کرد. در این معادله D سرعت رقیق شدن (بر ساعت)، F جریان (لیتر بر ساعت) و V حجم بیوراکتور (لیتر) است.
محیط کشت جدید را میتوان با سرعت ثابتی به بیوراکتور اضافه کرد. در این حالت سرعت اضافه شدن ترکیب محدودکننده ثابت میماند. در شرایطی ایستا سرعت تولید توده سلولی () را میتوان از اختلاف سرعت رشد سلولها در بیوراکتور () و سرعت خارج شدن سلولها از بیوراکتور () محاسبه کرد. در بخش قبلی توضیح دادیم که در شرایط ایستا این سرعت رشد و خروج سلولها با هم برابر و سرعت رشد صفر است. در این حالت اگر سرعت رقیق شدن سیستم از میکروارگانیسمها قبل از تقسیم شدن و افزایش تعداد سلولها از بیوراکتور خارج میشوند.
غلظت مقدار باقیمانده از ترکیب محدودکننده در حالت ایستا را برای سرعتهای رقیق شدن متفاوت میتوان با معادله زیر محاسبه کرد. در این معادله غلظت باقیمانده ترکیب محدودکننده در در حالت ثابت است.
معادله بالا را میتوان بهشکل نوشت. از تقسیم دو طرف این معادله به معادله زیر حاصل میشود.
در نتیجه باقیمانده ترکیب محدودکننده در بیوراکتورهای کشت مداوم به سرعت رقیق شدن بستگی دارد و تغییر سرعت رقیق شدن، سرعت رشد میکروارگانیسم را تغییر میدهد. ضریب بازدهی کشت مداوم در حالت ایستا به غلظت توده زیستی یا متابولیتهای میکروارگانیسم بستگی دارد. این دارامتر را با کمک گرفتن از معادله ضریب بازدهی کشت غیرمداوم میتوان با معادله زیر محاسبه کرد. در این معادله غلظت ترکیب محدودکننده در محیط کشت اضافه شده به بیوراکتور است.
اندازه گیری رشد میکروبی
اگر تا این بخش از مطلب سینتیک رشد میکروبی ما را همراهی کرده باشید، با مراحل رشد میکروارگانیسمها آشنا شدهاید، در این بخش قصد داریم روشهای اندازهگیری رشد میکرواوگانیسمهار ا با هم مرور کنیم. میزان رشد میکروبها در محیط کشت را میتوان با روشهای مستقیم و غیرمستقیم اندازهگیری کرد. شمارش تعداد سلولها در محیط کشت، شمارش کلونیها، اندازهگیری وزن خشک سلولی روشهای مستقیم و بررسی میزان کدورت محیط کشت، اندازهگیری غلظت محتویات سلولی (پروتئین، RNA و DNA)، تعیین مقدار ATP و غلظت مواد مصرف شده برای رشد، روش غیر مستقیم اندازهگیری میزان رشد میکروبها است.
شمارش سلول میکروبی با لام شطرنجی
برای شمارش تعداد سلولها از لامهای شطرنجی استفاده میشود. هر مربع بزرگ در این از ۱۶ مربع کوچکتر تشکیل شده است و حجم مشخصی از محفظه زیری را نشان میدهد. تعداد سلولهای در هر مربع بزرگ زیر میکروسکوپ شمرده میشود و تعداد سلولها در حجم کلی محیط کشت محاسبه میشود. شمارش سلولها با لام شطرنجی روشی سریع و ساده برای محاسبه رشد باکتری است. اما محدودیتهایی دارد. در این روش بدون رنگآمیزیهای تخصصی نمیتوان سلولهای مرده را از سلولهای زنده تشخیص داد. به دلیل اندازه کوچک سلولها و احتمال وجود ذرات اضافی در محیط کشت، اندازهگیری تعداد دقیق سلولها در این روش دشوار است. به علاوه سلولهای متحرک برای شمارش در این روش، باید کشته یا روی لام ثابت شوند.

شمارش کلونی میکروبی
یکی دیگر از روشهای اندازهگیری رشد میکروبی شمارش کلونیها است. از این روش میتوان برای شمارش میکروبهای زنده استفاده کرد. روش شمارش کلونی بر اساس این فرضیه طراحی شده است که هر کلونی محیط کشت به وسیله تقسیم و رشد یک سلول ایجاد شده است. بنابراین تعداد کلونیها نشاندهنده تعداد سلولها است. این روش حساسیت بالایی دارد و به کمک میتوان حتی یک میکروارگانیسم رنده را تشخیص داد. به همین دلیل در تشخیص آلودگیهای میکروبی صنایع غذایی از آن استفاده میشود.
محیط کشت این روش آگار است. برای کشت سلولها میتوان مقدار مشخصی از محلول میکروبها (معمولا ۰٫۱ میلیلیتر یا کمتر) را روی پلیت آگار پراکنده کرد یا ابتدا مقدار مشخصی از محلول میکروب (معمولا بین ۰٫۱ تا ۱ میلیلیتر) را در پلیت استریل ریخت و سپس آگار مایع (حدود ۵۰ درجهسانتیگراد) را به آن اضافه کرد. تعداد میکروبها در محیط کشت نباید خیلی زیاد یا خیلی کم باشد. اگر تعداد میکروبها خیلی زیاد باش، بعضی از سلولها کلونی تشکیل نمیدهند یا بعضی کلونیها با هم ادغام میشوند. اگر تعداد میکروبها بسیار کم باشد، شمارش سلولها از نظر آماری معنیدار نیست. پلیتهایی با ۳۰ تا ۳۰۰ کلونی، بهترین پلیتها برای شمارش تعداد سلول هستند.
اندازه گیری وزن خشک توده سلولی
اندازهگیری وزن خشک سلولی، میزان رشد میکروبها را بر اساس توده سلولی مشخص میکند و تعداد سلولها را نشان نمیدهد. این روش در اندازهگیری رشد باکتریها و کپکهای رشتهای کاربرد زیادی دارد. از این روش میتوان برای اندازهگیری رشد میکروبها در محیط جامد نیز استفاده کرد. برای اندازهگیری وزن خشک سلولی ابتدا میکروبها از محیط کشت جدا میشوند و ترکیبات اضافی آنها فیلتر میشود. سپس وزن رسوب ایجاد شده، پس از خشک شدن در دسیکاتور اندازهگیری میشود. در این روش نمیتوان سلولهای زنده را از سلولهای زنده جدا کرد.

اندازه گیری کدورت محیط کشت
رشد سلولها در محیط کشت مایع منجر به تغییر رنگ محیط و کدر شدن محیط کشت میشود. هر چه توده سلولی بیشتر باشد، کدورت محیط افزایش مییابد. از آنجا که سلولها بخشی از نور را جذب و بخشی از آن را پراکنده میکنند، از تابش نور به سلول و اندازهگیری میزان نور جذب شده میتوان برای اندازهگیری تعداد سلولها استفاده کرد. هر چه تعداد سلولها بیشتر باشد، میزان جذب نور بیشتر است. برای اندازهگیری میزان کدورت از دستگاه اسپکتروفتومتر یا طیفسنج استفاده میشود. در این دستگاه نور مرئی از یک منشور عبور میکند و به اشعههایی با طول موجهای مختلف تجزیه میشود. طول موج ۴۸۰ نانومتر (نور آبی)، ۵۴۰ نانومتر (نور سبز) و ۶۶۰ نانومتر (نور قرمز) متداولترین طول موجهایی است که در اندازهگیری کدروت میکروبها کاربرد دارد. در طیفسنجی نمودار میزان جذب به تغییرات زمان رسم میشود. این نمودار با نمودار استاندارد مقایسه و تعداد سلولهای تعیین میشود.
تعیین مقدار ATP
ATP یکی از اولین ترکیباتی است که از سلولهای مرده خارج میشود. به همین دلیل اندازهگیری غلظت آن به تعیین تعداد سلولهای زنده کمک میکند. لوسیفراز آنزیمی است که با مصرف ATP لوسیفرین را هیدرولیز و نور تولید میکند. از این واکنش برای تعیین مقدار ATP در نمونههای سلولی میکروارگانیسمها استفاده میشود. هر چه مقدار ATP (تعداد سلولهای مرده) بیشتر باشد، نور بیشتری تولید میکند.
عوامل موثر بر رشد میکروبی
سرعت تقسیم سلولی و رشد میکروارگانیسم با ویژگیهای فیزیکی و شیمیایی محیط تغییر میکند. در دسترس بودن مواد غذایی کافی برای رشد میکروبها ضروری است. اما تنها فاکتور تعیینکننده سرعت رشد نیست. دما، pH محیط، اسمولاریته و اکسيژن، عوامل مهمی هستند که سرعت رشد باکتری را تغییر میدهند. اگر یکی از این عوامل بیشتر یا کمتر از محدوده مورد نیاز باکتری باشد، رشد میکروارگانیسم متوقف میشود. در کشت مداوم و غیرمدام با خوراکدهی پیوسته میتوان تغییر این عوامل را کنترل کرد. در بخشهای قبلی این مطلب سینتیک رشد میکروبی را توضیح دادیم و در این بخش عوامل موثر بر رشد باکتریها را مرور میکنیم، اما اگر میخواهید اطلاعات بیشتری در مورد ساختار و متابولیسم انواع میکروارگانیسمها مشاهده فیلمهای آموزشی فرادرس که لینک آنها در ادامه آورده شده است به شما پیشنهاد میشود.
- فیلم آموزش میکروبیولوژی بخش یکم فرادرس
- فیلم آموزش میکروبیولوژی متابولیسم میکروارگانیسم ها فرادرس
- فیلم آموزش مبانی میکروبیولوژی زیست محیطی فرادرس
- فیلم آموزش میکروبیولوژی صنعتی فرادرس
دمای رشد میکروب
دمای رشد مناسب برای میکروارگانیسمهای مختلف، متفاوت است و به محیط طبیعی زندگی آنها بستگی دارد. افزایش دما سبب افزایش سرعت واکنشهای آنزیمی و رشد سریعتر رشد میکند. افزایش دما بیش از حداکثر تحمل میکروارگانیسم منجر به دناتوره شدن پروتئینها و سایر مولکولهای زیستی و مرگ سلول میشود. دمای بهینه رشد میکروبها متفاوت است. دمای بهینه رشد بعضی از میکروبها صفر درجه سانتیگراد و دمای بهینه از آنها ۱۰۰ درجه سانتیگراد است. میکروبها بر اساس دمای بهینه رشد به انواع سایکروفیل، مزوفیل، ترموفیل و هایپرترموفیل تقسیم می شوند. سایکروفیلها در دمای پایین، مزوفیلها در دمای معتدل، ترموفیلها در دمای بالا و هایپرترموفیلها در دمای بسیار بالا رشد میکنند.
pH رشد میکروب
pH بهینه محیط برای رشد میکروبها متفاوت است. بعضی از میکروبها در pH اسیدی (اسیدوفیل)، بعضی از میکروبها در pH خنثی (نوتروفیل) و بعضی از میکروبها در محیط کشت (آلکالیفیل) رشد میکنند. بعضی از باکتریها اسیدهای آلی تولید میکنند که رشد سایر میرکوبها در محیط کشت را مهار میکند. به علاوه بعضی از ساختار بعضی از ترکیبات محیط کشت با تغییر pH تغییر میکند. به همین دلیل تنظیم pH محیط کشت و ثابت نگهداشتن آن رای رشد میکروبها بسیار مهم است.
اکسیژن رشد میکروب
میکروبها بر اساس نیاز به اکسیژن به انواع هوازی، هوازی اختیاری و غیرهوازی تقسیم میشوند. میکروبهای هوازی بدون حضور اکسیژن و میکروبهای بیهوازی در حضو اکسیژن رشد نمیکنند. میکروبهای هوازی اختیاری در محیطهای دارای اکسيژن و بدون اکسيژن رشد میکنند. به علاوه بعضی از میکروبها (میکروائروفیل) برای رشد به مقدار بسیار کم اکسيژن نیاز دارند. تنظیم اکسيژن برای رسیدن به رشد بهینه در محیط کشت ضروری است.
اسمولاریته محیط کشت میکروب
تغییر غلظت نمکها معدنی و متابولیتهای آلی محیط کشت سبب تغییر اسمولاریته آن میشود. افزایش غلظت متابولیتها و کاهش آب در محیط منجر به خارج شدن آب از سیتوپلاسم و جمع شدن سلولها میشود. کاهش متابولیتها و افزایش غلظت آب محیط کشت منجر به ورود آب از محیط کشت به سیتوپلاسم و تورم سلول میشود. در این شرایط ممکن است میکروب لیز شود و از بین برود.
جمعبندی سینتیک رشد میکروبی
در این مطلب از مجله فرادرس توضیح دادیم که سینتک رشد میکروبی، رشد باکتریها در واحد زمان را نشان میدهد. این پارامتر در محیط کشتهای صنعتی اهمیت زیادی دارد. در صنایع مختلف از میکروبها برای تولید موادغذایی، آنزیمهای صنعتی، داروهای مختلف، محلولهای شیمیایی و تصفیه فاضلاب استفاده میشود. آشنایی با فرایند رشد میکروارگانیسمها، عواملی که رشد آنها را تغییر میدهد و سینتیک رشد میکروبی به متخصصان میکروبیولوژی صنعتی کمک میکند تا بهرهروی و کارایی تولید محصولات را افزایش دهند.
در این مطلب توضیح دادیم که برای کشت میکروارگانیسم ها از محیطهای جامد و مایع استفاده میشود. از محیط کشت مایع برای کشت میکروارگانیسمها به روش غیرمداوم، مداوم و غیرمداوم با خوراک پیوسته استفاده میشود. در روش غیرمداوم میکرواوگانیسم در حجم مشخصی از محیط کشت رشد میکند و با تمام شدن مواد غذایی محیط کشت، رشد سلولها متوقف میشود. در روش مداوم محیط کشت با سرعت ثابت به مخزن رشد میکروارگانیسمها اضافه میشود و باکتری تا زمان در درسترس بودن موادغذایی، رشد میکند. در روش غیرمداوم با خوراک پیوسته، محیط کشت جدید زمانی به مخزن رشد باکتری اضافه میشود که مقدار مواد غذایی کاهش یافته باید.
در بخشهای پایانی مطلب سینتیک میکروبی توضیح دادیم که رشد میکروبها در محیط کشت با شمارش سلولها، زیر میکروسکوپ، بررسی کدورت محیط کشت مایع، مشاهده کلونیها زیر میکروسکوپ، تعیین غلظت ATP در محیط کشت و اندازهگیری وزن خشک میکروارگانیسمها بررسی میشود. همچنین توضیح دادیم که علاوه بر غلظت موادغذایی، تغییرات pH، دما، مقدار اکسیژن و اسمولاریتی محیط سرعت رشد میکروارگانیسمها را تغییر میدهد.













